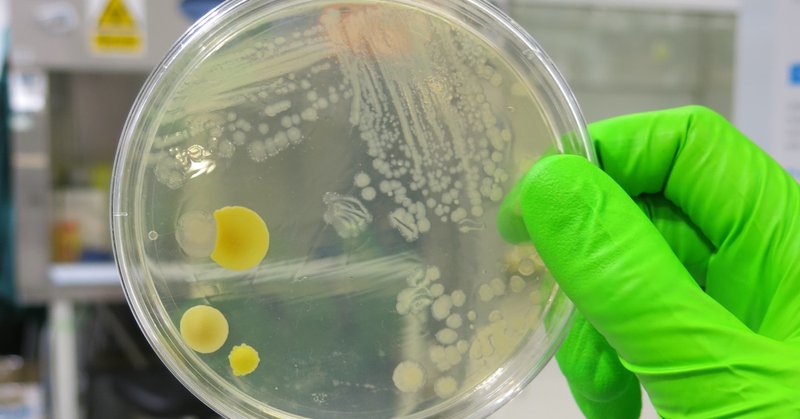

Andrew Singer
@OxonAndrew
Followers
6K
Following
18K
Media
4K
Statuses
16K
Environmental Microbiologist, Pollution Scientist; 327.66 ppm CO2 #AMR #OneHealth #WBE #CSO
Wallingford, England
Joined March 2012
🚨 SWIMMERS & NON-SWIMMERS WANTED! Swum in a river/lake in the past 2 weeks? Felt unwell, or totally fine? Help inform public health research. 🏊♀️🧍♂️ 📋 Take part: https://t.co/sj7oFyQJxA 🔍 More info: https://t.co/WrlJWBhkaM
@UniofExeterNews @ExeterMed @RachSalv @leanahosea
1
15
14
Tackling #AMR @AMR_DHH. This episode features Laura Shallcross @UCL_IHI; Mark Sutton @UKHSA and @KingsCollegeLon; @OxonAndrew @UK_CEH; and Colin Brown @UKHSA. https://t.co/FqzgqflsMS
thenakedscientists.com
When the drugs no longer beat the bugs...
1
7
13
12
137
195
Did you read our paper on “Water industry strategies to manufacture doubt and deflect blame for sewage pollution in England”? https://t.co/u8vI0GjRzV This tweet is textbook disinformation. You will not end sewage entering our rivers and seas. You’re misleading the public.
nature.com
Nature Water - In the past 5 years, a huge amount of untreated wastewater has been released into English waterways. An analysis of the communication used by the water utilities shows that they have...
Water companies have proposed to invest more than £11 billion over the next five years to upgrade our sewers and end sewage entering our rivers and seas. Learn more: https://t.co/jXa2UeJB2j
1
21
35
Research out today finds English “water companies are adopting disinformation tactics similar to those used by fossil fuel & tobacco industries with the widespread use of greenwashing to downplay environmental harm they cause”. 👇 https://t.co/BSxk9yrEnX 👏👏 @Jamie_Woodward_ &
theguardian.com
Researchers say companies have prolonged injustice and exaggerated cost of solving infrastructure problems
7
246
503
Water industry strategies to manufacture doubt and deflect blame for sewage pollution in England @Jamie_Woodward_ @watervole3 @OxonAndrew @DrAlexFord
https://t.co/Y9bfPMrAS9
nature.com
Nature Water - In the past 5 years, a huge amount of untreated wastewater has been released into English waterways. An analysis of the communication used by the water utilities shows that they have...
1
52
68
New report exposes just how water companies keep polishing those turds... @DrAlexFord @Jamie_Woodward_ @OxonAndrew @WindrushWasp @watervole3 on strategies of downplaying, dismissing & misrepresentation employed to mask the extent of sewage pollution. https://t.co/CMwGY0ocqM
4
61
118
Yay! Our play has been favourably reviewed! 🙌🏼
#REVIEW - Panacea at @cockpittheatre "a profoundly moving play that transcends its simple synopsis" https://t.co/FAptKm8O0G
1
0
3
It was brilliant - really recommend! On tonight, tomorrow and Sunday so still time to watch. 🙂🦠
Opening night tonight!!!!! 😱🙀🦇✍️🧬🔬🥼🧪 https://t.co/RCYAx7z93P
0
1
2
PANACEA 9-12 Jan A cutting-edge tragedy about a brilliant scientist who creates an infectious vaccine that could save humanity from a future pandemic! Science meets neurodiversity & the traditions of Greek tragedy in this bold piece of new writing https://t.co/1f7rkQJAfo
0
2
3
Opening night tonight!!!!! 😱🙀🦇✍️🧬🔬🥼🧪 https://t.co/RCYAx7z93P
0
0
3
I’m so excited to share this play with everyone! It has been a journey and a learning experience to transition from science-day-job to play write and dramaturge…but I’m loving it! https://t.co/AfvD1kEpSt Playing Thursday through Sunday this week!! #Autism #Science #Vaccine
Contemporary science meets the classical traditions of Greek tragedy in this bold piece of new writing PANACEA 9 - 12 Jan A brilliant scientist creates an infectious vaccine that could save humanity from a future pandemic. Produced by Bloodline Theatre https://t.co/1f7rkQJAfo
1
2
7
PANACEA 9 - 12 Jan A modern tragedy that follows brilliant but lonely scientist Gus as he navigates the complexities of medical consent and romantic relationships with Autism. Produced & presented by Bloodline Theatre https://t.co/1f7rkQJAfo
#theatre #londontheatre #autism
0
2
1
I'm excited to share that I co-wrote a play, "Panacea" @cockpittheatre Jan 9-12 The play centres around a Senior Medical Microbiologist at a UK University focused on research that aims to develop an infectious vaccine (based on real research). Details
0
0
11
🚨 PhD opportunity 🚨 Want to be part of the research effort tackling the global problem of #AMR? Interested in tracking #pathogens and AMR in aquatic systems using MST & omics methods? Then come and do a #PhD with us! See below for the details⬇️ 🦠🧫🧬 @UK_CEH @UniofBath
1
11
27
Bathing water reforms to consider water sports and water quality Defra invites the public, community and environmental groups, farmers, businesses and local authorities to share views on modernising bathing water regulations. https://t.co/ovcMJpieKP
gov.uk
Defra invites the public, community and environmental groups, farmers, businesses and local authorities to share views on modernising bathing water regulations.
0
5
11
A frightening account of West Nile Viral infection by Dr Fauci! https://t.co/spJr2UVozx via @nytopinion
nytimes.com
What it’s like to get the neglected disease.
0
0
0
I’m sure we can sit on an our hands for another few decades before addressing this one..don’t you think? “Rivers dried up at the highest rate in three decades in 2023, putting global water supply at risk, data has shown.”
theguardian.com
World Meteorological Organization says water is ‘canary in the coalmine of climate change’ and calls for urgent action
0
1
3